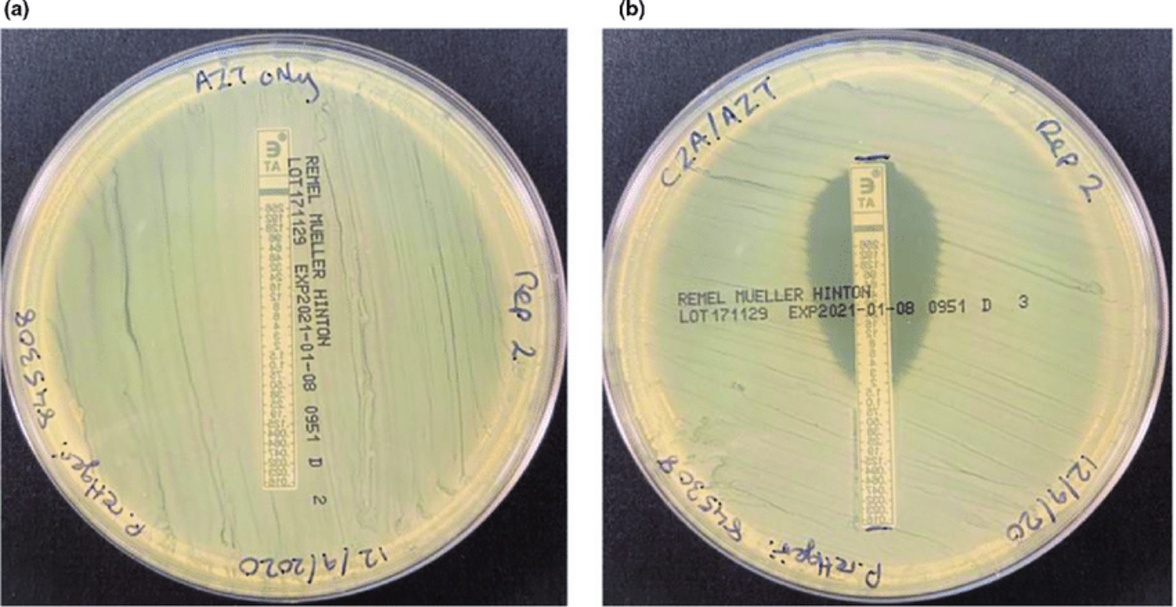
Азтреонам-авибактам эффективен против патогенов с MDR

Азтреонам-авибактам оказался эффективным при лечении госпитализированных взрослых пациентов с критической формой грамотрицательных бактериальных инфекций с множественной лекарственной резистентностью, согласно результатам исследования REVISIT фазы 3.
Результаты, представленные на конференции IDWeek, свидетельствуют о том, что новая комбинация антибиотиков компании Pfizer хорошо переносится и сопоставима по эффективности с меропенемом, что может стать новым вариантом лечения грамотрицательных инфекций, в том числе вызванных патогенами с множественной лекарственной резистентностью (MDR), продуцирующими металло-бета-лактамазы.
Иегуда Кармели, руководитель Израильского национального центра антибиотикорезистентности в Тель-Авиве, и его коллеги провели исследование среди взрослых, госпитализированных с осложненными внутрибрюшными инфекциями (ОВБИ) и внутрибольничной или вентилятор-ассоциированной пневмонией (ВБП/ВАП), вызванными бактериями с MDR. По данным исследователей, 422 участника были рандомизированы в соотношении 2:1 и получали либо азтреонам-авибактам (ATM-AVI) с метронидазолом или без него, либо меропенем с колистином или без него. Те, кто заболел ОВБИ, получали лечение в течение 5-14 недель, а те, кто заболел ВБП/ВАП, - в течение 7-14 недель.
Двумя первичными конечными результатами исследования были клиническое излечение на этапе контроля лечения (TOC) в популяции намерения к лечению (ITT) и среди клинически оцениваемой подгруппы пациентов. Вторичные конечные результаты включали микробиологические реакции на этапе ТОС, смертность в течение 28 дней и безопасность комбинации препаратов.
Согласно пресс-релизу компании Pfizer, опубликованному в начале этого года, частота излечения в группе ITT среди пациентов с ОВБИ, получавших исследуемую комбинацию препаратов, составила 76,4% против 74% среди пациентов, получавших меропенем, - разница составила 2,4%. В подгруппе пациентов с ОВБИ, у которых можно было провести клиническую оценку, частота излечения составила 85,1% при использовании ATM-AVI и 79,5% при использовании меропенема.
В пресс-релизе компании Pfizer также сообщается, что среди пациентов в группе ITT с ВБП/ВАП частота излечения составила 45,9% при использовании ATM-AVI и 41,7% при использовании меропенема, а разница в лечении составила 4,3%. Среди клинически оцениваемых пациентов с ВБП/ВАП частота излечения составила 46,7% против 54,5%. Исследователи сообщили, что благоприятный микробиологический ответ на этапе TOC в подгруппе ITT составил 75,7% при использовании ATM-AVI и 73,9% при использовании меропенема. Кроме того, 28-дневная летальность составила 1,9% в группе ATM-AVI и 2,9% в группе меропенема.
По словам исследователей, ATM-AVI хорошо переносился, и серьезных побочных явлений, связанных с лечением, не наблюдалось. Компания Pfizer в своем релизе отметила, что по уровню безопасности эта комбинация аналогична азтреонаму. Компания Pfizer заявила, что планирует использовать эти данные, а также результаты предыдущего исследования ASSEMBLE, для начала процесса получения разрешения на применение ATM-AVI в конце этого года.
"Эти клинические данные показывают, что ATM-AVI, если он будет одобрен, может помочь обеспечить защиту от грамотрицательных бактерий без ущерба для эффективности и безопасности", - говорится в пресс-релизе компании. "Эти данные особенно многообещающи, учитывая сложности лечения инфекций ОВБИ и ВБП/ВАП у госпитализированных пациентов с тяжелыми заболеваниями, а также трудности набора пациентов в данной популяции", - отметил Кармели.